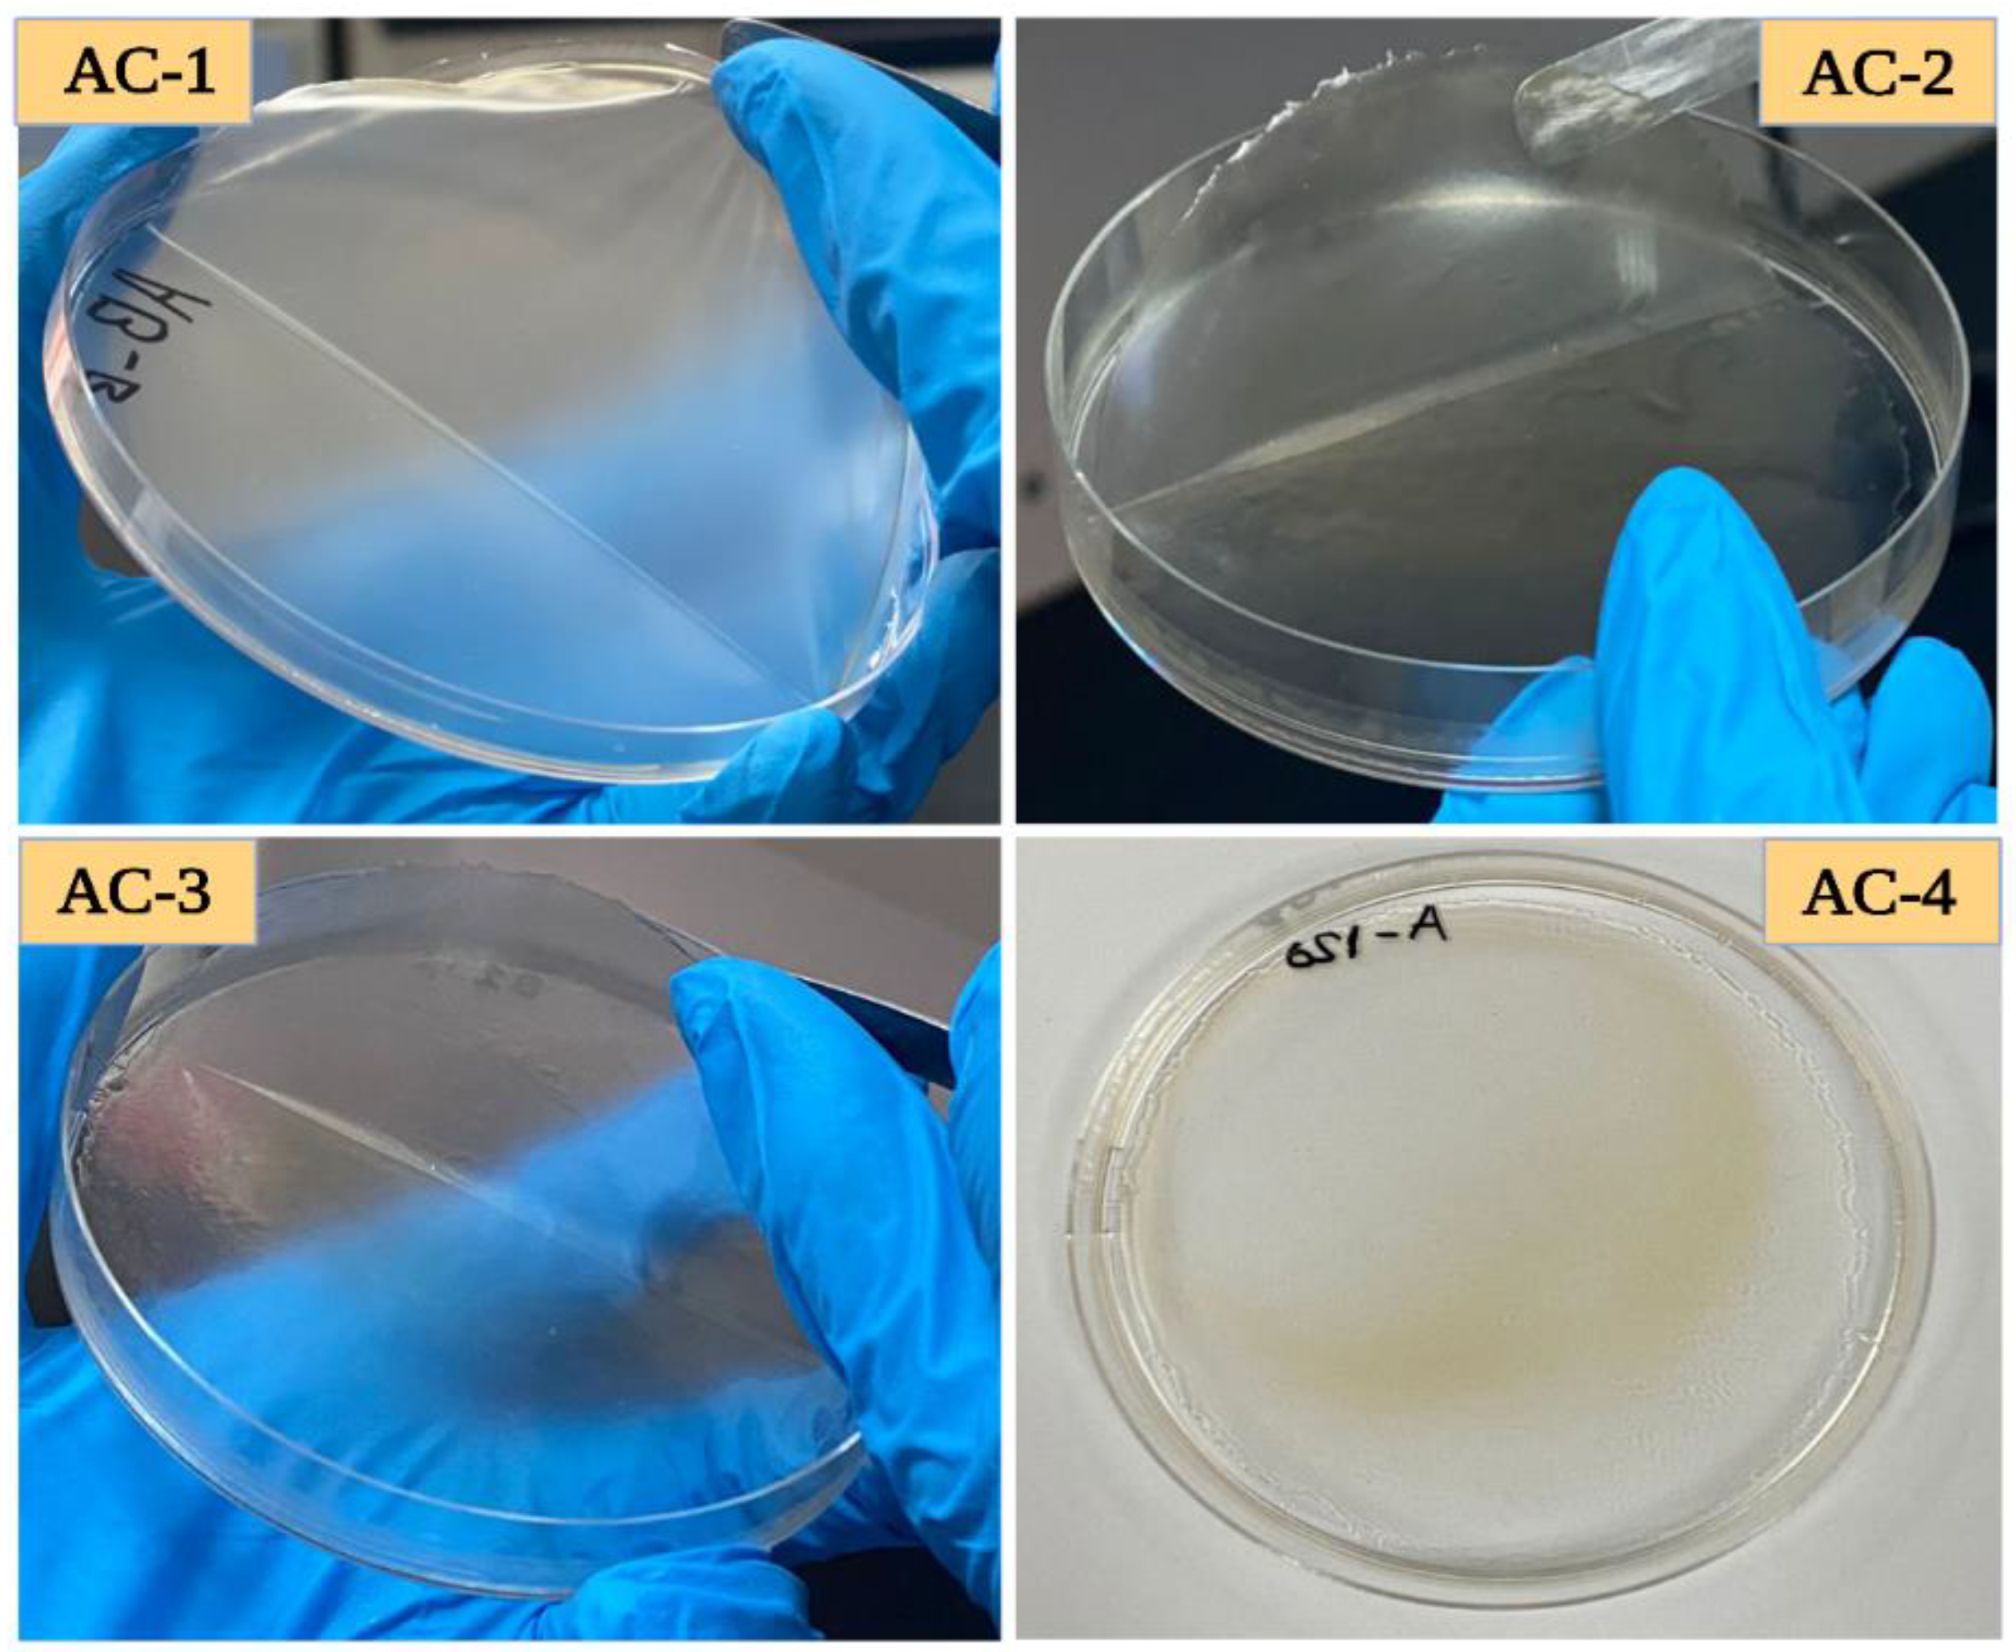
Gels 09 00337 g001

Fabrication, Characterization, and Antioxidant Potential of Sodium Alginate/Acacia Gum Hydrogel-Based Films Loaded with Cinnamon Essential Oil
Abstract
1. Introduction
2. Results and Discussion
2.1. Visual Assessment of the Films
2.2. Thickness of the Films
2.3. Mechanical Properties of the SA–AG-Based Films
2.4. Moisture Content
2.5. Water Vapor Permeability
2.6. Transparency and Color Parameters
2.7. Scanning Electron Microscopy
2.8. X-ray Diffraction Analysis
2.9. Fourier Transform Infrared Spectroscopy
2.10. DSC Analysis
2.11. Antioxidant Potential
3. Conclusions
4. Materials and Methods
4.1. Film-Formation
4.2. Thickness
4.3. Mechanical Properties
4.4. Moisture Content
4.5. Water Vapor Permeability
4.6. Transparency and Color Parameters
4.7. Microstructure of the Films
4.8. X-ray Diffraction (XRD) Analysis
4.9. Fourier Transforms Infrared Spectroscopy (FT-IR)
4.10. Differential Scanning Calorimetry
4.11. Antioxidant Analysis
4.12. Statistical Analysis
Author Contributions
Funding
Institutional Review Board Statement
Informed Consent Statement
Data Availability Statement
Acknowledgments
Conflicts of Interest
References
- Dhumal, C.V.; Sarkar, P. Composite edible films and coatings from food-grade biopolymers. J. Food Sci. Technol. 2018, 55, 4369–4383. [Google Scholar] [CrossRef]
- Ibrahim, A.G.; Abdel Hai, F.; Abd El-Wahab, H.; Aboelanin, H. Methylene blue removal using a novel hydrogel containing 3-Allyloxy-2-hydroxy-1-propanesulfonic acid sodium salt. Adv. Polym. Technol. 2018, 37, 3561–3573. [Google Scholar] [CrossRef]
- Ibrahim, A.G.; Sayed, A.Z.; Abd El-Wahab, H.; Sayah, M.M. Synthesis of a hydrogel by grafting of acrylamide-co-sodium methacrylate onto chitosan for effective adsorption of Fuchsin basic dye. Int. J. Biol. Macromol. 2020, 159, 422–432. [Google Scholar] [CrossRef]
- Elkony, A.M.; Ibrahim, A.G.; Abu El-Farh, M.H.; Abdelhai, F. Synthesis of Acrylamide-co-3-Allyloxy-2-hydroxy-1-propanesulfonic acid sodium salt Hydrogel for efficient Adsorption of Methylene blue dye. Int. J. Environ. Anal. Chem. 2021, 103, 1–20. [Google Scholar] [CrossRef]
- Galus, S.; Lenart, A. Development and characterization of composite edible films based on sodium alginate and pectin. J. Food Eng. 2013, 115, 459–465. [Google Scholar] [CrossRef]
- Gheorghita, R.; Gutt, G.; Amariei, S. The use of edible films based on sodium alginate in meat product packaging: An eco-friendly alternative to conventional plastic materials. Coatings 2020, 10, 166. [Google Scholar] [CrossRef]
- Mahcene, Z.; Khelil, A.; Hasni, S.; Akman, P.K.; Bozkurt, F.; Birech, K.; Goudjil, M.B.; Tornuk, F. Development and characterization of sodium alginate based active edible films incorporated with essential oils of some medicinal plants. Int. J. Biol. Macromol. 2020, 145, 124–132. [Google Scholar] [CrossRef] [PubMed]
- Dou, L.; Li, B.; Zhang, K.; Chu, X.; Hou, H. Physical properties and antioxidant activity of gelatin-sodium alginate edible films with tea polyphenols. Int. J. Biol. Macromol. 2018, 118, 1377–1383. [Google Scholar] [CrossRef] [PubMed]
- Liu, S.; Li, Y.; Li, L. Enhanced stability and mechanical strength of sodium alginate composite films. Carbohydr. Polym. 2017, 160, 62–70. [Google Scholar] [CrossRef]
- Sanchez, C.; Nigen, M.; Tamayo, V.M.; Doco, T.; Williams, P.; Amine, C.; Renard, D. Acacia gum: History of the future. Food Hydrocoll. 2018, 78, 140–160. [Google Scholar] [CrossRef]
- Suresh, S.N.; Puspharaj, C.; Natarajan, A.; Subramani, R. Gum acacia/pectin/pullulan-based edible film for food packaging application to improve the shelf-life of ivy gourd. Int. J. Food Sci. Technol. 2022, 57, 5878–5886. [Google Scholar] [CrossRef]
- Ibrahim, A.G.; Elkony, A.M.; El-Bahy, S.M. Methylene blue uptake by gum arabic/acrylic amide/3-allyloxy-2-hydroxy-1-propanesulfonic acid sodium salt semi-IPN hydrogel. Int. J. Biol. Macromol. 2021, 186, 268–277. [Google Scholar] [CrossRef]
- Kang, S.; Xiao, Y.; Guo, X.; Huang, A.; Xu, H. Development of gum arabic-based nanocomposite films reinforced with cellulose nanocrystals for strawberry preservation. Food Chem. 2021, 350, 129199. [Google Scholar] [CrossRef]
- Pelissari, F.M.; Grossmann, M.V.; Yamashita, F.; Pineda, E.A.G. Antimicrobial, mechanical, and barrier properties of cassava starch− chitosan films incorporated with oregano essential oil. J. Agric. Food Chem. 2009, 57, 7499–7504. [Google Scholar] [CrossRef] [PubMed]
- Gómez-Estaca, J.; De Lacey, A.L.; López-Caballero, M.; Gómez-Guillén, M.; Montero, P. Biodegradable gelatin–chitosan films incorporated with essential oils as antimicrobial agents for fish preservation. Food Microbiol. 2010, 27, 889–896. [Google Scholar] [CrossRef]
- Wu, Y.; Luo, Y.; Wang, Q. Antioxidant and antimicrobial properties of essential oils encapsulated in zein nanoparticles prepared by liquid–liquid dispersion method. LWT-Food Sci. Technol. 2012, 48, 283–290. [Google Scholar] [CrossRef]
- Nwanade, C.F.; Wang, M.; Wang, T.; Zhang, X.; Zhai, Y.; Zhang, S.; Yu, Z.; Liu, J. The acaricidal activity of cinnamon essential oil: Current knowledge and future perspectives. Int. J. Acarol. 2021, 47, 446–450. [Google Scholar] [CrossRef]
- Wang, R.; Wang, R.; Yang, B. Extraction of essential oils from five cinnamon leaves and identification of their volatile compound compositions. Innov. Food Sci. Emerg. Technol. 2009, 10, 289–292. [Google Scholar] [CrossRef]
- Deng, X.; Liao, Q.; Xu, X.; Yao, M.; Zhou, Y.; Lin, M.; Zhang, P.; Xie, Z. Analysis of essential oils from cassia bark and cassia twig samples by GC-MS combined with multivariate data analysis. Food Anal. Methods 2014, 7, 1840–1847. [Google Scholar] [CrossRef]
- Zhou, Y.; Wu, X.; Chen, J.; He, J. Effects of cinnamon essential oil on the physical, mechanical, structural and thermal properties of cassava starch-based edible films. Int. J. Biol. Macromol. 2021, 184, 574–583. [Google Scholar] [CrossRef]
- Gooderham, N.J.; Cohen, S.M.; Eisenbrand, G.; Fukushima, S.; Guengerich, F.P.; Hecht, S.S.; Rietjens, I.M.; Rosol, T.J.; Davidsen, J.M.; Harman, C.L. FEMA GRAS assessment of natural flavor complexes: Clove, cinnamon leaf and West Indian bay leaf-derived flavoring ingredients. Food Chem. Toxicol. 2020, 145, 111585. [Google Scholar] [CrossRef]
- Wu, J.; Sun, X.; Guo, X.; Ge, S.; Zhang, Q. Physicochemical properties, antimicrobial activity and oil release of fish gelatin films incorporated with cinnamon essential oil. Aquac. Fish. 2017, 2, 185–192. [Google Scholar] [CrossRef]
- Wu, J.; Liu, H.; Ge, S.; Wang, S.; Qin, Z.; Chen, L.; Zheng, Q.; Liu, Q.; Zhang, Q. The preparation, characterization, antimicrobial stability and in vitro release evaluation of fish gelatin films incorporated with cinnamon essential oil nanoliposomes. Food Hydrocoll. 2015, 43, 427–435. [Google Scholar] [CrossRef]
- Jamróz, E.; Juszczak, L.; Kucharek, M. Development of starch-furcellaran-gelatin films containing tea tree essential oil. J. Appl. Polym. Sci. 2018, 135, 46754. [Google Scholar] [CrossRef]
- Bhatia, S.; Al-Harrasi, A.; Al-Azri, M.S.; Ullah, S.; Bekhit, A.E.-D.A.; Pratap-Singh, A.; Chatli, M.K.; Anwer, M.K.; Aldawsari, M.F. Preparation and physiochemical characterization of bitter Orange oil loaded sodium alginate and casein based edible films. Polymers 2022, 14, 3855. [Google Scholar] [CrossRef]
- Suput, D.; Lazic, V.; Pezo, L.; Markov, S.; Vastag, Z.; Popovic, L.; Rudulovic, A.; Ostojic, S.; Zlatanovic, S.; Popovic, S. Characterization of starch edible films with different essential oils addition. Pol. J. Food Nutr. Sci. 2016, 66, 277–285. [Google Scholar] [CrossRef]
- Sánchez-González, L.; Vargas, M.; González-Martínez, C.; Chiralt, A.; Cháfer, M. Characterization of edible films based on hydroxypropylmethylcellulose and tea tree essential oil. Food Hydrocoll. 2009, 23, 2102–2109. [Google Scholar] [CrossRef]
- Tongnuanchan, P.; Benjakul, S.; Prodpran, T. Physico-chemical properties, morphology and antioxidant activity of film from fish skin gelatin incorporated with root essential oils. J. Food Eng. 2013, 117, 350–360. [Google Scholar] [CrossRef]
- Atarés, L.; Bonilla, J.; Chiralt, A. Characterization of sodium caseinate-based edible films incorporated with cinnamon or ginger essential oils. J. Food Eng. 2010, 100, 678–687. [Google Scholar] [CrossRef]
- Marzbani, P.; Resalati, H.; Ghasemian, A.; Shakeri, A. Surface modification of talc particles with phthalimide: Study of composite structure and consequences on physical, mechanical, and optical properties of deinked pulp. BioResources 2016, 11, 8720–8738. [Google Scholar] [CrossRef]
- Chan, H.; Nyam, K.; Yusof, Y.; Pui, L. Investigation of properties of polysaccharide-based edible film incorporated with functional melastoma malabathricum extract. Carpathian J. Food Sci. Technol. 2020, 12, 120–134. [Google Scholar]
- Venkatesham, M.; Ayodhya, D.; Madhusudhan, A.; Veerabhadram, G. Synthesis of stable silver nanoparticles using gum acacia as reducing and stabilizing agent and study of its microbial properties: A novel green approach. Int. J. Green Nanotechnol. 2012, 4, 199–206. [Google Scholar] [CrossRef]
- Altiok, D.; Altiok, E.; Tihminlioglu, F. Physical, antibacterial and antioxidant properties of chitosan films incorporated with thyme oil for potential wound healing applications. J. Mater. Sci. Mater. Med. 2010, 21, 2227–2236. [Google Scholar] [CrossRef] [PubMed]
- Kaya, M.; Khadem, S.; Cakmak, Y.S.; Mujtaba, M.; Ilk, S.; Akyuz, L.; Salaberria, A.M.; Labidi, J.; Abdulqadir, A.H.; Deligöz, E. Antioxidative and antimicrobial edible chitosan films blended with stem, leaf and seed extracts of Pistacia terebinthus for active food packaging. RSC Adv. 2018, 8, 3941–3950. [Google Scholar] [CrossRef]
- Sobral, P.d.A.; Menegalli, F.; Hubinger, M.; Roques, M. Mechanical, water vapor barrier and thermal properties of gelatin based edible films. Food Hydrocoll. 2001, 15, 423–432. [Google Scholar] [CrossRef]
- Hosseini, S.F.; Rezaei, M.; Zandi, M.; Farahmandghavi, F. Bio-based composite edible films containing Origanum vulgare L. essential oil. Ind. Crops Prod. 2015, 67, 403–413. [Google Scholar] [CrossRef]
- Aliheidari, N.; Fazaeli, M.; Ahmadi, R.; Ghasemlou, M.; Emam-Djomeh, Z. Comparative evaluation on fatty acid and Matricaria recutita essential oil incorporated into casein-based film. Int. J. Biol. Macromol. 2013, 56, 69–75. [Google Scholar] [CrossRef]
- Scartazzini, L.; Tosati, J.; Cortez, D.; Rossi, M.; Flôres, S.; Hubinger, M.; Di Luccio, M.; Monteiro, A. Gelatin edible coatings with mint essential oil (Mentha arvensis): Film characterization and antifungal properties. J. Food Sci. Technol. 2019, 56, 4045–4056. [Google Scholar] [CrossRef]
- Qin, Y.; Li, W.; Liu, D.; Yuan, M.; Li, L. Development of active packaging film made from poly (lactic acid) incorporated essential oil. Prog. Org. Coat. 2017, 103, 76–82. [Google Scholar] [CrossRef]
- Magalhaes, M.; Manadas, B.; Efferth, T.; Cabral, C. Chemoprevention and therapeutic role of essential oils and phenolic compounds: Modeling tumor microenvironment in glioblastoma. Pharmacol. Res. 2021, 169, 105638. [Google Scholar] [CrossRef]
- Suryanti, V.; Wibowo, F.; Khotijah, S.; Andalucki, N. Antioxidant activities of cinnamaldehyde derivatives. In Proceedings of the IOP Conference Series: Materials Science and Engineering, Kuala Lumpur, Malaysia, 13–14 August 2018; p. 012077. [Google Scholar]
- Xu, T.; Gao, C.; Feng, X.; Yang, Y.; Shen, X.; Tang, X. Structure, physical and antioxidant properties of chitosan-gum arabic edible films incorporated with cinnamon essential oil. Int. J. Biol. Macromol. 2019, 134, 230–236. [Google Scholar] [CrossRef]
- Tongnuanchan, P.; Benjakul, S.; Prodpran, T. Comparative studies on properties and antioxidative activity of fish skin gelatin films incorporated with essential oils from various sources. Int. Aquat. Res. 2014, 6, 62. [Google Scholar] [CrossRef]
- Tongnuanchan, P.; Benjakul, S.; Prodpran, T. Properties and antioxidant activity of fish skin gelatin film incorporated with citrus essential oils. Food Chem. 2012, 134, 1571–1579. [Google Scholar] [CrossRef] [PubMed]
- Pires, C.; Ramos, C.; Teixeira, B.; Batista, I.; Nunes, M.; Marques, A. Hake proteins edible films incorporated with essential oils: Physical, mechanical, antioxidant and antibacterial properties. Food Hydrocoll. 2013, 30, 224–231. [Google Scholar] [CrossRef]
- Properties, A.S.D.o.M. Standard Test Method for Tensile Properties of Thin Plastic Sheeting. Available online: https://www.wewontech.com/testing-standards/190125019.pdf (accessed on 12 March 2023).
- Erdem, B.G.; Dıblan, S.; Kaya, S. Development and structural assessment of whey protein isolate/sunflower seed oil biocomposite film. Food Bioprod. Process. 2019, 118, 270–280. [Google Scholar] [CrossRef]
- Zhao, J.; Wang, Y.; Liu, C. Film Transparency and Opacity Measurements. Food Anal. Methods 2022, 15, 2840–2846. [Google Scholar] [CrossRef]
- Brand-Williams, W.; Cuvelier, M.; Berset, C. Antioxidative activity of phenolic composition of commercial extracts of sage and rosemary. LWT 1995, 28, 25–30. [Google Scholar] [CrossRef]
- Re, R.; Pellegrini, N.; Proteggente, A.; Pannala, A.; Yang, M.; Rice-Evans, C. Antioxidant activity applying an improved ABTS radical cation decolorization assay. Free Radic. Biol. Med. 1999, 26, 1231–1237. [Google Scholar] [CrossRef] [PubMed]

| Film Sample | Thickness (mm) | Tensile Strength (Mpa) | Elongation at Break (%) | Moisture Content (%) | Water Vapor Permeability ((g * mm)/(m2 * h * kPa)) |
|---|---|---|---|---|---|
| AC-1 | 0.065 ± 0.006 a | 9.82 ± 0.41 a | 7.57 ± 0.45 a | 18.52 ± 0.41 a | 0.424 ± 0.018 a |
| AC-2 | 0.075 ± 0.006 a | 7.31 ± 0.65 b | 12.24 ± 0.60 b | 18.18 ± 0.39 ab | 0.405 ± 0.007 a |
| AC-3 | 0.098 ± 0.005 b | 5.59 ± 0.27 c | 14.94 ± 0.79 c | 17.89 ± 0.59 bc | 0.390 ± 0.015 b |
| AC-4 | 0.110 ± 0.006 c | 3.49 ± 0.02 d | 18.41 ± 0.60 d | 17.03 ± 0.08 c | 0.353 ± 0.004 c |
| Film Sample | Transparency (%) | L | a* | b* | ΔE* |
|---|---|---|---|---|---|
| AC-1 | 79.99 ± 0.62 a | 96.05 ± 0.12 a | −0.08 ± 0.02 a | 0.94 ± 0.08 a | 0.85 ± 0.09 a |
| AC-2 | 73.85 ± 2.04 b | 94.40 ± 0.07 b | 0.03 ± 0.03 b | 2.68 ± 0.11 b | 2.98 ± 0.10 b |
| AC-3 | 64.02 ± 1.05 c | 92.39 ± 0.30 c | 0.05 ± 0.02 b | 3.42 ± 0.47 c | 4.36 ± 0.43 c |
| AC-4 | 21.23 ± 2.27 d | 91.64 ± 0.15 d | 0.26 ± 0.05 c | 4.97 ± 0.52 d | 5.04 ± 0.54 c |
Disclaimer/Publisher’s Note: The statements, opinions and data contained in all publications are solely those of the individual author(s) and contributor(s) and not of MDPI and/or the editor(s). MDPI and/or the editor(s) disclaim responsibility for any injury to people or property resulting from any ideas, methods, instructions or products referred to in the content. |
© 2023 by the authors. Licensee MDPI, Basel, Switzerland. This article is an open access article distributed under the terms and conditions of the Creative Commons Attribution (CC BY) license (https://creativecommons.org/licenses/by/4.0/).
Share and Cite
Bhatia, S.; Al-Harrasi, A.; Shah, Y.A.; Altoubi, H.W.K.; Kotta, S.; Sharma, P.; Anwer, M.K.; Kaithavalappil, D.S.; Koca, E.; Aydemir, L.Y. Fabrication, Characterization, and Antioxidant Potential of Sodium Alginate/Acacia Gum Hydrogel-Based Films Loaded with Cinnamon Essential Oil. Gels 2023, 9, 337. https://doi.org/10.3390/gels9040337
Bhatia S, Al-Harrasi A, Shah YA, Altoubi HWK, Kotta S, Sharma P, Anwer MK, Kaithavalappil DS, Koca E, Aydemir LY. Fabrication, Characterization, and Antioxidant Potential of Sodium Alginate/Acacia Gum Hydrogel-Based Films Loaded with Cinnamon Essential Oil. Gels. 2023; 9(4):337. https://doi.org/10.3390/gels9040337
Chicago/Turabian StyleBhatia, Saurabh, Ahmed Al-Harrasi, Yasir Abbas Shah, Halima Waleed Khalifa Altoubi, Sabna Kotta, Priyanka Sharma, Md. Khalid Anwer, Deepa Sreekanth Kaithavalappil, Esra Koca, and Levent Yurdaer Aydemir. 2023. "Fabrication, Characterization, and Antioxidant Potential of Sodium Alginate/Acacia Gum Hydrogel-Based Films Loaded with Cinnamon Essential Oil" Gels 9, no. 4: 337. https://doi.org/10.3390/gels9040337
APA StyleBhatia, S., Al-Harrasi, A., Shah, Y. A., Altoubi, H. W. K., Kotta, S., Sharma, P., Anwer, M. K., Kaithavalappil, D. S., Koca, E., & Aydemir, L. Y. (2023). Fabrication, Characterization, and Antioxidant Potential of Sodium Alginate/Acacia Gum Hydrogel-Based Films Loaded with Cinnamon Essential Oil. Gels, 9(4), 337. https://doi.org/10.3390/gels9040337

